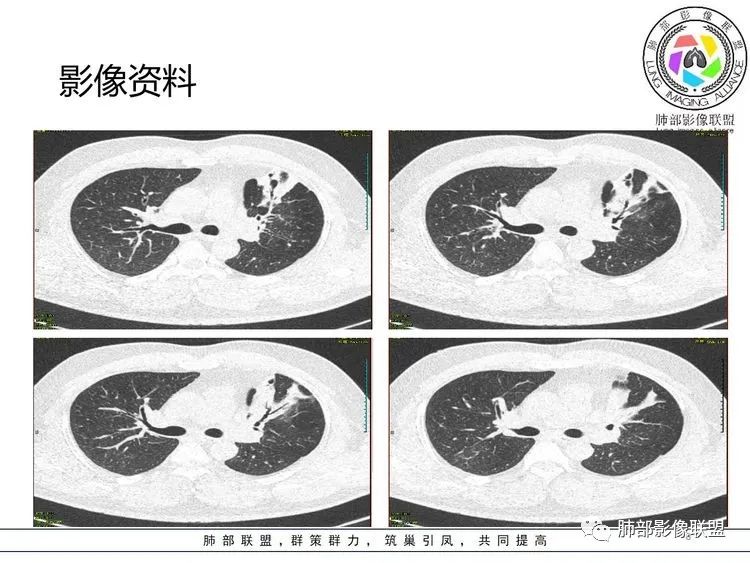
【病例】支原体肺炎-8

【病例】支原体肺炎
发布时间:2022-10-22
发布时间:2022-10-22

![]()
张延军: 左肺上叶前段沿支气管束周围见实变影,边缘收缩,界不清,内见小空洞影,与支气管相通,病变周围散在结节及斑片状高密度影,树芽征(+),中年男性,类似结核中毒症状,感染指标升高,考虑NTM,结核代排。
joyzhy:中年男性,咳嗽咳痰,炎性指标升高。影像,左肺上叶片状实变,部分平直,部分内收,支气管血管束增厚,头孢类治疗后效果不佳。考虑非典型肺炎,支原体?鉴别:吸入性肺炎
放射小白: 首先考虑NTM,鉴别OP,还是看看各位老师分析。
twn: malt、OP
琦遇:范围:结核、NTN、奴卡、淋巴瘤
若晗:左肺上叶空洞伴树芽!结合临床及发病部位,考虑NTM可能性大,鉴别奴卡
衡妈:左上肺感染性病变,支原体?
青藤之凉: @刘海玲 义工滨海县人民医院影像 ,有什么特点吗?
你为何不随大流;NTM、TB为何不首先@刘海玲 义工滨海县人民医院影像
紫气东来: 结核,鉴别NTm
琦遇: 铜绿?
支原体不太可能吧?病史上看也不符合。这例有支扩
衡妈: 实变+支气管充气征,可见支气管壁增厚,病灶边缘模糊磨玻璃。我没有看到树芽;NTM 一般要有背景 比如支扩
最后一束散射线: 树芽看见了也可以是支原体啊
青藤之凉: 实质病变还是间质
衡妈: 这个实变为主;少许间质
张丽红: 有发热,咳嗽呼吸道感染症状。左肺上叶斑片影,内部支气管走行自然。右肺也有散在斑片影。考虑非结核分枝杆菌,结核
青藤之凉: @万琦 辽宁沈阳结核医院 说说为何就不可能
衡妈: 对 支原体也可以树芽
琦遇: 树芽–树雾征,然后实变,
青藤之凉: 树芽、树雾是支原体特点 。这个是吗?
琦遇: 对
衡妈:

尘缘: 单从影像和病史来看,肯定首先考虑结核,鉴别支原体,尽管多了那么多结核阴性的检查,结核还是要考虑。再查一下支原体抗原抗体吧。
良孑:实变,虫蚀样空洞,树芽,还是首选TB
衡妈:

里面这个气泡 支原体很少看见
采莲: 中年男性,咳嗽咳痰伴发热10天,血象CRP升高,血沉快,但白细胞及中性粒细胞比例没有明显升高,左肺上叶斑片实变影,支气管通而不畅,考虑肺炎、肺结核可能性大,但是肺泡灌洗液Xpert阴性,t-spot阴性,肺结核可能性就小了,不排除NTM,但是NTM在上叶的不多见。实在想不出来,血象不高,支原体肺炎真有可能。
青藤之凉: @达州红十字医院 尹发友 TB长成这个样子的也不多呀
琦遇: 如果是这样的支原体肺炎,病史不会这么短
没看到树芽,说实话也不太像结核。
前几天有个淋巴瘤病例,感觉很类似
是支气管扩张还是空洞? 没有视频不太好判断
青藤之凉: 感觉病变以间质分布为主对吧
采莲: 我只是觉得如果是结核肺泡灌洗液Xpert阳性率是很高的,这人是中年,免疫力不错的话tspot阳性率也是很高的。
青藤之凉: 其实我拿到病例时首先就考虑了NTM
病变主要以间质为主
琦遇: 铜绿可以吗?
谢加平: OP肺炎; 支气管内壁锯齿状,牵引性扩张,实变与胸膜形成拱形桥特点。
若晗: 那这样肯定不是了l
琦遇: 支扩基础上的
尘缘: 铜绿不考虑
最后一束散射线: 老师们考虑OP么
本例结果:

结果后讨论与总结:
采莲: 其实我觉得结核和NTM都不像,但没想到支原体,刘老师一说支原体,觉得真有可能。
琦遇: 怎么看也不像呀?
采莲: 有结核呀。
尘缘: 所以我的思路还是对的。支原体肺炎相对常见啊

洪桥爱: @达州红十字医院 尹发友 何老师的病例,尹院长考虑的结核,是上肺的树丫,还是支气管周围的实变影?
尘缘: @洪桥爱 湘西自治州人民医院感染科 上肺的树芽加支气管爬行像结核。
青藤之凉: 下面我们再看几例巩固下,看图说话。


青藤之凉: 我发的病例考虑什么?
张延军: 支气管走形自然,磨玻璃区有小网格,间质分布,病毒,支原体。
衡妈: 支原体咯血吗?
青藤之凉: 天天搞难的,来点简单实用的多好
尘缘: @李洁,云南德宏医院 树雾(支扩加周围改变),间质,高热,非典啊,支原体可能最大。
青藤之凉: 别想多了。都是常见,临床实用型。到底什么,直接给答案,不用分析
邢瑞欣: 支原体感染咳血吗?
衡妈:


衡妈: 刚李老师发的病例 考虑非典。
张延军: 支原体?树雾状改变
青藤之凉: 高热三件套?哪一件?
尘缘: @邢瑞欣日照莒县人民医院影像科 可以引起咳血啊,累及间质,间质充血,血管壁渗出,不就咯血了
张延军: 腺病毒,鹦鹉热,军团菌
衡妈: 66岁了 支原体还是少
最后一束散射线: 年龄大,猜鸟
青藤之凉: 结果:肺炎链球菌。
肺炎链球菌一般起始于肺外周的气腔,贴近脏层胸膜表面或者叶间裂。通常不累及支气管,表现为肺实质炎症。不穿过叶间裂等解剖屏障。会有肺叶膨胀。
衡妈: 但是一看大家考虑 支原体 赶快撤。
青藤之凉: 继续下一个啊,考虑啥?
![]()

琦遇: 肺克。
青藤之凉: 我的病例都是绿色,大家大胆说,没坑
张丽红: 链球菌。
张延军: 克雷白。空洞,叶间裂下坠
若晗: 支持肺克
食客: 肺克、结核?
尘缘: 支持吸入性肺克
琦遇: 粘液性腺癌
青藤之凉: 肺炎克雷伯菌,大家都对了。
肺炎克雷伯菌有局限性,因为痰液粘稠,会造成叶间裂膨出。肺内可能会有蜂窝样改变。有糖尿病、吸烟、支气管病病史者,容易感染肺炎克雷伯菌。可能会有空洞形成,右肺上叶发病最常见。
青藤之凉: 最后一例?

最后一束散射线: 然后下一个是金葡了?
张丽红: 支原体
若晗: 支原体
最后一束散射线: 支原体
衡妈: 支原体
若晗: 结节十树芽十树雾
deng: 这个支原体了
张世晓: 支原体
青藤之凉: 支原体肺炎的影像特征相对比较明显。有支气管壁增厚、支气管扩张样改变、支气管充气征。小叶小结节,有点状或者斑片状的浸润影、有实变影,表现为树芽征、树雾气征。
张延军: 树雾征,支原体感染
青藤之凉: 临床特点:①临床轻,影像重,病程较长。②儿童和青少年发病。
影像学特点:①支气管壁增厚、支气管周围炎。②腺泡结节、树芽征、树雾征(见病例1)。③结节融合,大片实变,部分边缘收缩。④分布上较广泛 。
支原体开始、支原体结束,还有很多感染类型需要学习。以后有时间我们在一起学习,今天病例就分析到这里,感谢大家的陪伴。
支原体肺炎小结:
肺炎支原体是介于细菌和病毒之间,能独立生活的最小微生物,无细胞壁,能独立生存引起人类感染的原核细胞,在有氧和无氧环境中均能生长,具有细菌的某些特性,是常见的非典型病原体。主要好发于儿童和青年人,一般预后良好,偶有发展为ARDS和间质纤维化。临床表现包括发热、咳嗽等,无特异性,病程相对较长,常在2周至4周。实验室检查可表现为白细胞水平正常或轻度升高。
支原体肺炎的发病机理及病理变化:其主要通过呼吸道传播。支原体侵入肺组织细胞后,可黏附于呼吸道黏膜纤毛上皮并进行破坏,从而引起肺间质的充血、水肿及炎性细胞浸润(影像特点,气道壁增厚,树芽征,局部岛状),病变再沿支气管、肺血管鞘周围发展并侵犯到肺泡间隔,引起肺间质的炎性改变,在此基础上进而引起肺泡病变,并随着病情的发展而产生一系列的肺炎并发症(树雾征未积极抗感染就会发展成大叶性实变)。也有研究认为,支原体肺炎是支原体进入机体后,诱发了人体的体液免疫和细胞免疫,表现为急相蛋白升高。据研究,支原体肺炎发病率较高,并且有逐年增高的趋势,不同时间血清的支原体抗体滴度呈4倍增高是目前临床确诊支原体肺炎的主要依据。
支原体肺炎CT影像特点及其临床意义:支原体肺炎的CT影像学特点是1.密度较低、边缘模糊、云雾状分布的阴影,云雾状阴影从肺门向肺外周分布,通常称为磨玻璃状阴影。2.肺实质受累时,还会出现肺实变,出现大片的实变阴影。3.支原体肺炎的CT影像也可以看到间质性浸润结节状或网状的阴影,阴影呈截断性分布。
总之如果ct表现为间质性的改变,同时伴有咳嗽,咳白痰,高热,头痛,精神萎靡,恶心呕吐等症状时,我们可以考虑支原体的感染可能。如果患者支原体的感染,在近期出现了四倍以上的升高,我们可确诊为支原体的感染,确诊为支原体感染后,我们需要进行积极的治疗,常用的药物包括了大环内酯类的抗生素,例如红霉素,阿奇霉素。但目前来说大环内酯类抗生素耐药性较高,首选还是喹诺酮类抗生素如莫西沙星、左氧氟沙星。